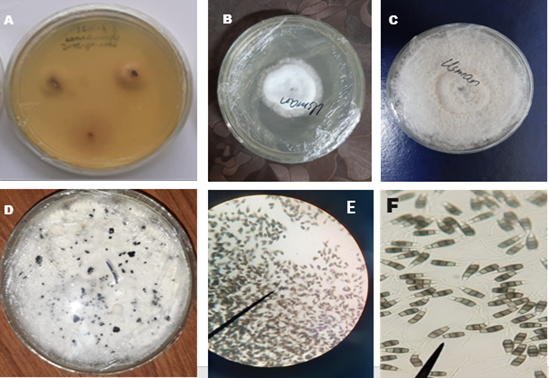

Application of Silver Nanoparticles and Fungicides for in vitro Suppression of Pestalotiopsis psidii, a Pathogen Associated with Guava Stem Cracking
DOI:
https://doi.org/10.55627/pbiotech.003.02.1315Keywords:
Guava, Stem Cracking, Pestalotiopsis psidii, Fungicides, Silver nanoparticlesAbstract
Guava (Psidium guajava L) is a widely cultivated fruit plant in tropical and subtropical countries, including Pakistan, where it is attacked by numerous pathogenic fungi. Guava stem cracking is caused by a destructive disease that significantly affects the stem and other parts of the plant. This study was conducted to isolate the causative pathogen of stem cracking and its management with chemicals and silver nanoparticles (AgNPs). Samples were obtained from seven different locations of Punjab, Pakistan, and the pathogen was isolated and purified on PDA using the hyphal tip technique. After the confirmation of pathogenicity, spore suspension was plated in a 96-well plate for chemical evaluation and a 9-day-old culture was used to find the AgNPs effect by the agar dilution method. Antifungal activity was measured in terms of optical density (OD) for chemicals and percent growth inhibition (PGI) for AgNPs. Four fungicides (Mancozeb, Iprodione, Chlorothalonil and Deconil) were evaluated at 7 different concentrations (50mg/ml, 25 mg/ml, 12.5 mg/ml, 6.25 mg/ml, 3.12 mg/ml, 1.56 mg/ml and 0.78 mg/ml) against P. psidii and the maximum antifungal effect was seen at the concentration of 50mg/ml. In vitro evaluation of fungicides showed Iprodione maximum spore growth inhibition against P. psidii. Silver nanoparticles were used to analyze their antifungal potential at different concentrations (1 ppm, 10 ppm, 100 ppm), whereas the maximum inhibition zone was seen at 100 ppm of AgNPs. Data was statistically analyzed by using factorial design under Complete Randomized Design (CRD). The outcomes of the present study revealed that using chemicals and silver nanoparticles can help to manage guava stem canker.
References
Downloads
Published
Issue
Section
License
Copyright (c) 2025 Ameer Hamza Aslam, Usman Ahmad, Rabia Irshad, Muhammad Faheem Khan, Zia Ullah Ashraf, Muhammad Usman, Abdul Muhaimin Nadeem, Amjad Abbas (Author)

This work is licensed under a Creative Commons Attribution 4.0 International License.





